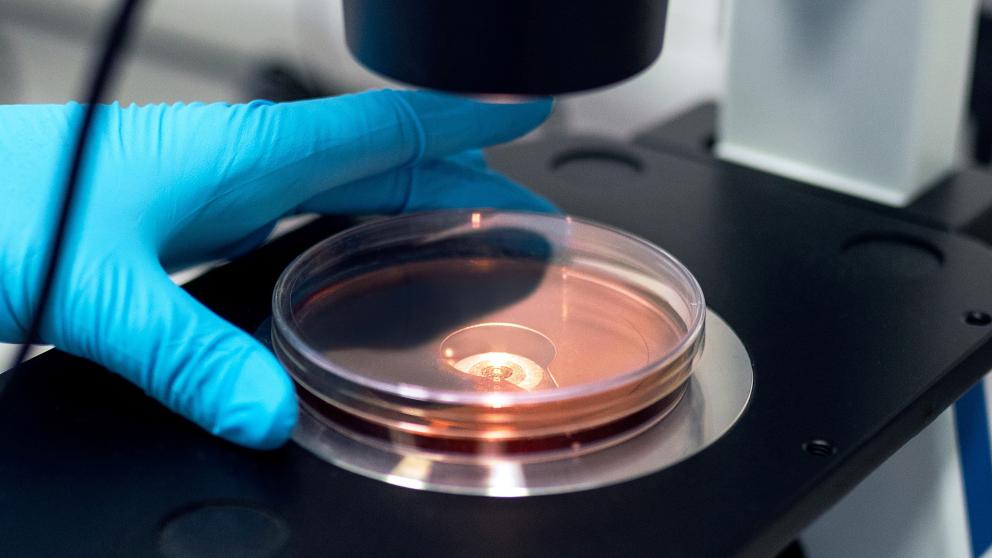
Biomedicine

Celebrating International Day of Women and Girls in Science
This weekend, Saturday 11th February, marks the eighth annual celebration of International Day of Women and Girls in Science. This day was established in 2015 to recognise the talent and importance of women in STEM (science, technology, engineering and mathematics) careers.
Kirsty Carlyle (pictured below), Biomedical Engineer and PHD student at the University of Salford’s EPSRC Centre for Doctoral Training in Prosthetics and Orthotics (CDT), is an advocate for women and girls in STEM, both in her personal life and through the University.
From growing up around her grandparents, who benefitted from the use of medical technology themselves in their day-to-day lives, Kirsty always knew she wanted a career in which she could combine her love of science, maths and design, with helping people.
After a few setbacks in breaking the glass ceiling into a male dominated profession, she reflects: “I thought I wasn’t smart enough for STEM, but I just hadn’t found the right area. Looking back, I wish I knew biomedical engineering existed sooner.
“STEM is so diverse and there is so much you can do. You can combine your interests and what you’re passionate about with your skillset. Don’t lose sight of that imagination and creativity. People often get put off by exams, but by asking the right questions, you really can add your own flair to everything you do. There is always space.”
Realising that other people might have a similar misunderstanding of what STEM involves, Kirsty set out to raise awareness of how crucial it is to have women in these careers. She explains: “All I can do is tell my story and hope it resonates with people.”
At University in Glasgow, Kirsty became president of the Female Engineering Society. Growing her confidence in entering a male-dominated discipline, she went on to participate in and run many projects and workshops, both in the UK and around the globe.
She visited Rwanda in 2018 to collaborate with female engineers. They worked side by side in order to show young children that it is possible to enter and succeed in the STEM industry. Assisting with the curation of a hugely successful society, Kirsty taught a number of young girls the soft skills and interview techniques they may find beneficial going forward. She worked with and all-female team of engineers from Rwanda, to organise industry visits and workshops for over 6500 school children.
After taking part in a scholarship in Florida, Kirsty also founded the FemEng in Malawi project. Collaborating with the Malawi University of Science and Technology, the Glasgow-based FemEng society created a student-led team, to deliver an outreach project. Despite having to move online due to Covid-19, this proved to be equally as successful. With initial concern for the organisation of the event and quality of delivery, Kirsty said, “The end goal was to encourage female participation in the events. We realised we didn’t need to send a large number of students out to Malawi in order to get our message across. The project revolved around encouragement, hope and creativity.
“The students from Malawi were able to deliver in-person talks. It’s so important not only for the projects to go ahead, but also for them to be run by local people who are relatable, and have a better understanding of what is needed to encourage girls and women in the area to get into STEM careers.”
Reflecting on what once held her back, Kirsty says her message to any female wanting to enter a STEM career would be: “You don’t need to conform to the stereotypes, or change yourself in any way. You don’t need to be ‘one of the lads’ or pigeonhole yourself into being either creative or academic to be successful. You can combine these things and that’s okay. Just go for it.”
For all press office enquiries please email communications@salford.ac.uk.
Share:
